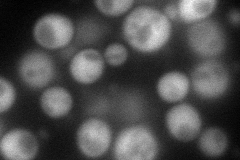
YIL145C
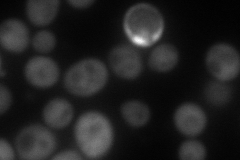
YIL145C
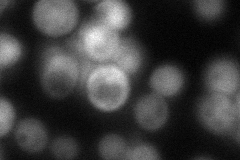
YIL145C
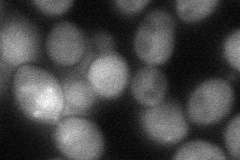
YIL145C
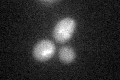
YIL145C

View description
Pantothenate synthase, also known as pantoate-beta-alanine ligase, required for pantothenic acid biosynthesis, deletion causes pantothenic acid auxotrophy, homologous to E. coli panC
Localization:
Intensity:
Fold change:
Significance:
-
C’ GFP library in SD

below threshold15.51 -
N' NOP1pr-GFP in SD
cytosol123.096 -
N' TEF2pr-mCherry in SD
cytosol151.342 -
N' NATIVEpr-GFP in SD
cytosol64.5775 -
N' TEF2pr-VC and Cyto-VN in SD
cytosol52.0339 -
C’ GFP library in SD+DTT
cytosol16.861.08No -
C’ GFP library in SD+H2O2

cytosol16.41.05No -
C’ GFP library in Starvation Media

cytosol17.471.12No -
C’ GFP library on the background of Pup2-DaMP

N/A -
C’ GFP library on the background of CCT mutant

N/A0N/AYes
